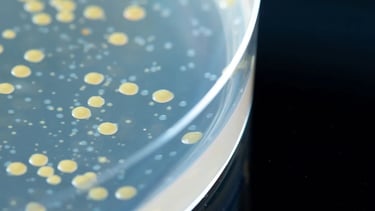

GMP Quality Control


GMP Quality Control
One focus of our activity is the testing of drugs, biotherapeutics, and medical devices in accordance with the methods of pharmacopeia. We also offer the testing of all required raw materials for production, such as active ingredients, excipients, and packaging materials. We offer a quick, reliable and prompt service. With modern, comprehensive equipment and the experience of over twenty years in performing analytical analysis, we are able to provide sophisticated and efficient solutions at any time. Right from the preparation of the testing sample and its analysis up to the compilation of the related documentation.
Testing of Active Ingredients and Excipients (Analytics in accordance with the methods of the relevant pharmacopoeia (Ph.Eur., USP, BP, JP, CP)
Testing of Finished Products in the Field of Human and Veterinary Pharmaceuticals, Biotherapeutics, Medical Devices (Testing according to pharmacopoeia or customer method)
Testing of Packaging Materials
Implementation of Analytical Methods including Transfer, Monitoring and Reporting
Testing of Semi-Finished Goods
Testing of Small Scale Batches and Batches from Development (from phase 1 to market)
GMP Testing
GMP Quality Control
Method Development & Validation






Dissolution
Extractables & Leachables






Particle Determination
Elemental Impurities Testing






Regulatory Services
Amino Acid Analysis

N-nitrosamines
qPCR






Protein Characterization






Bioassay
Stability Studies
Packaging Material Testing
Microbiology
Instrumentation
cIEF


Limit test for DEG and EG by GC
Our Services
The experienced and highly committed GBA Pharma Labs team offers a variety of different services in the following Areas.
QUALITY
GMP Testing
GBA Pharma GmbH
Anna-Sigmund-Straße 7
82061 Neuried
GBA Pharma GmbH
Ernst-Abbe-Straße 40
89079 Ulm
Trust
Expertise
Tel. +49 173 889 4251
© 2025. All rights reserved.